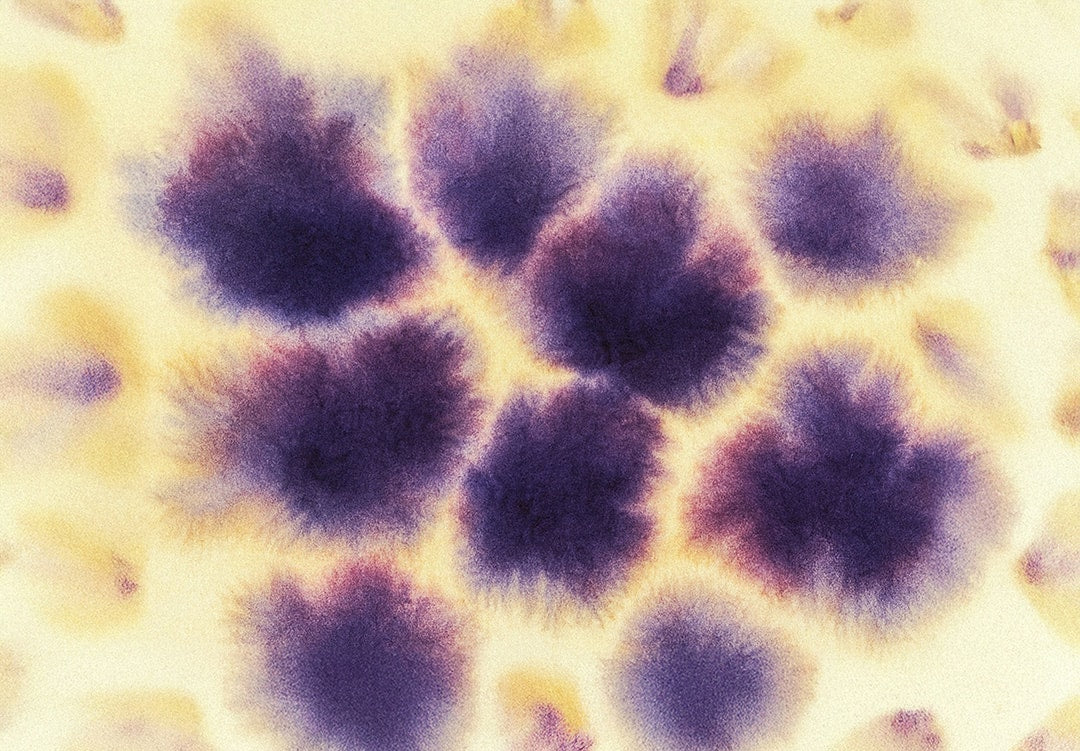

The Liquid Picnic Circle of Care
Three moods. One flow. Your skin, your senses, your story.

They compliment each other
Each blend complements the others — like chapters of one story:
Forest Affair awakens your senses.
Jant Jubilee celebrates your radiance.
Oil of Noonight restores your inner calm.
Together, they form a complete rhythm of care — a 24-hour ritual for presence, play, and renewal.

Full-circle care for morning, day, and night

Adapts to your skin’s changing needs and moods

Ideal for gifting or discovering your favorite ritual

Small-batch, vegan, natural & made with love in Germany























